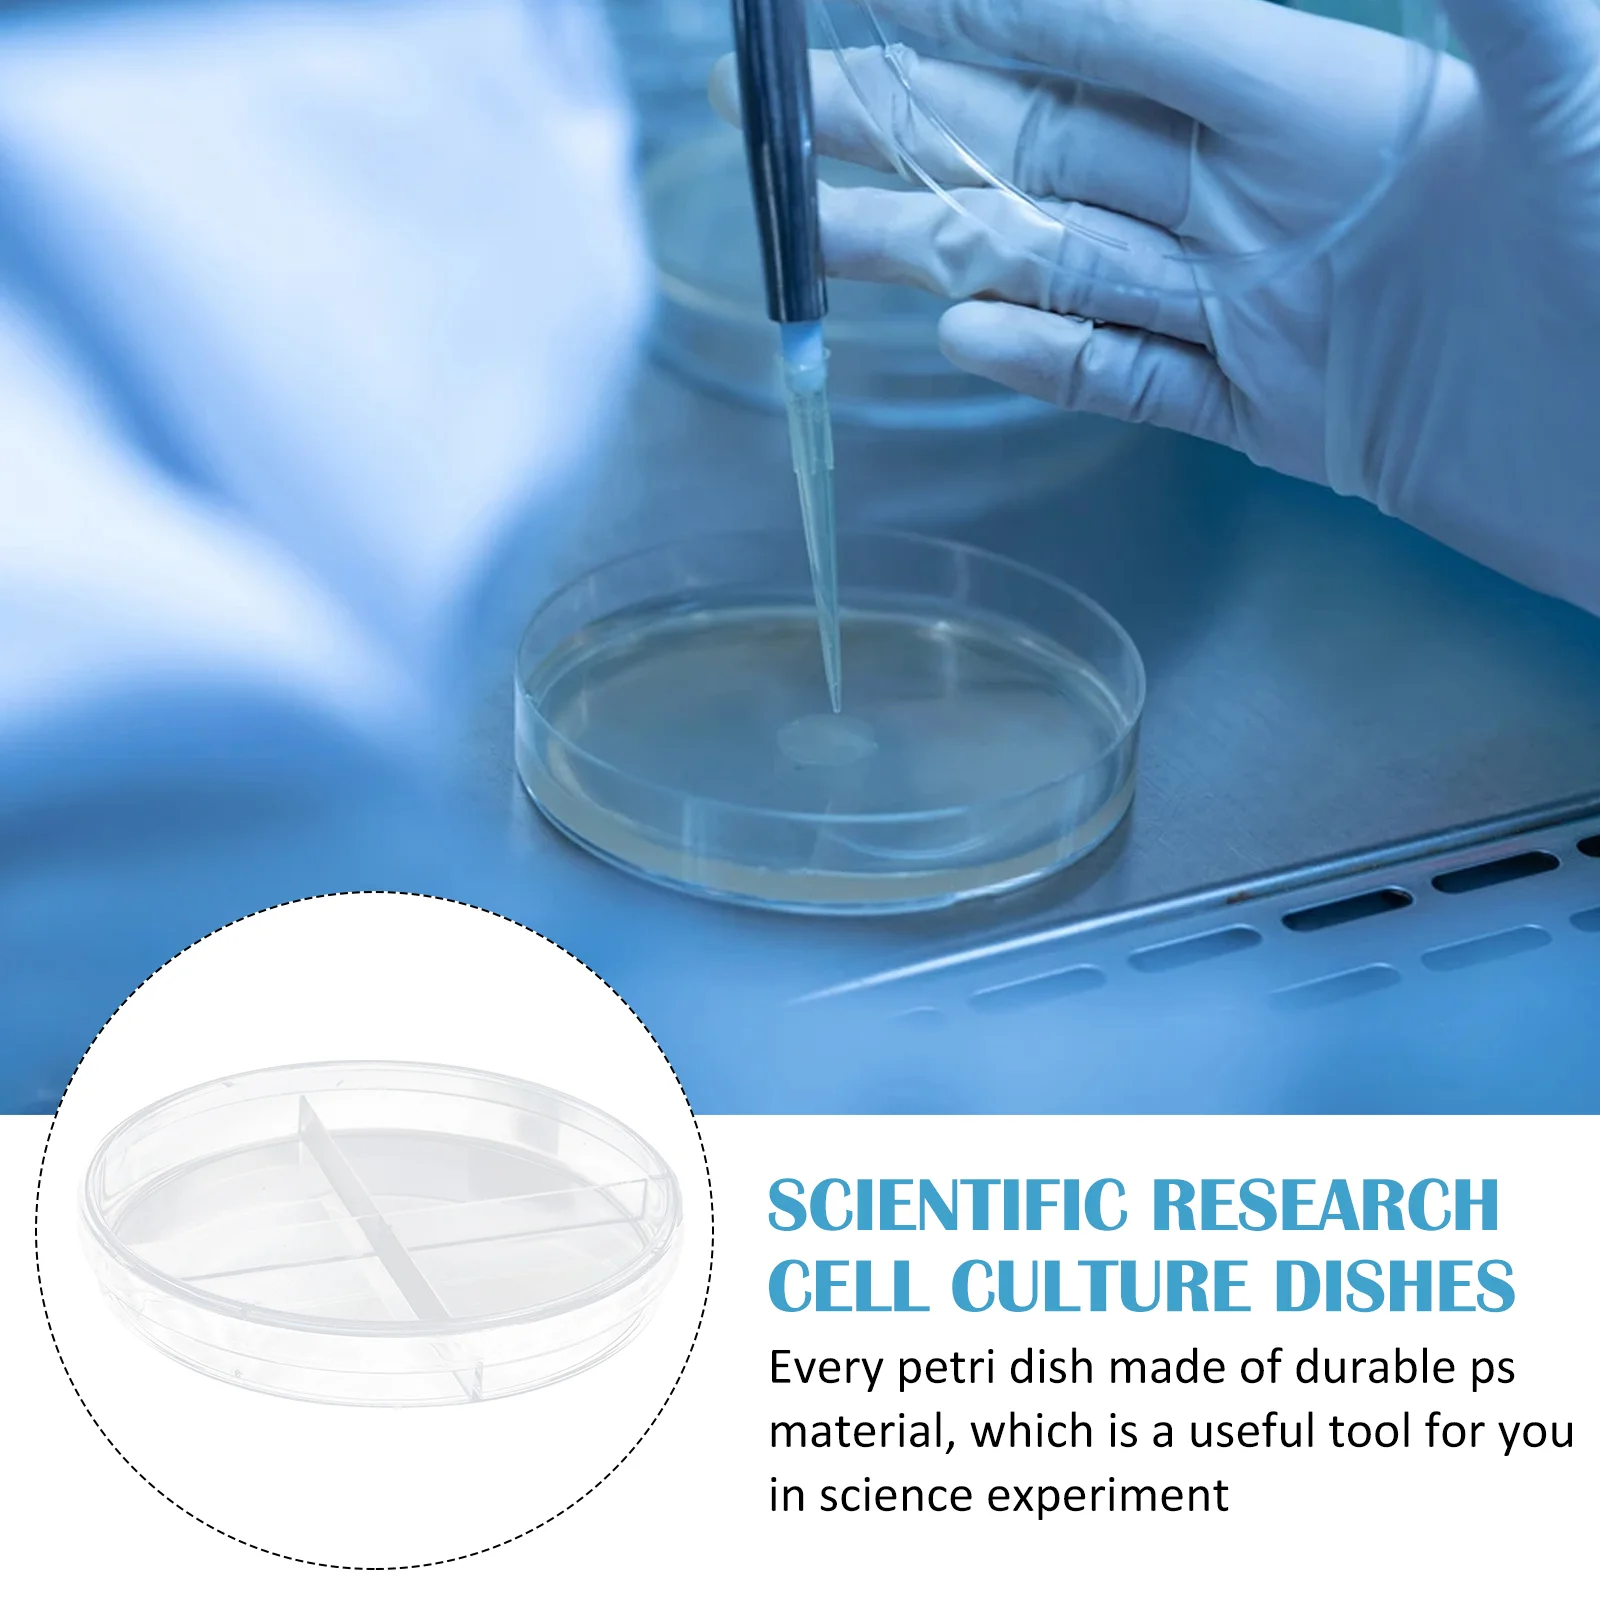
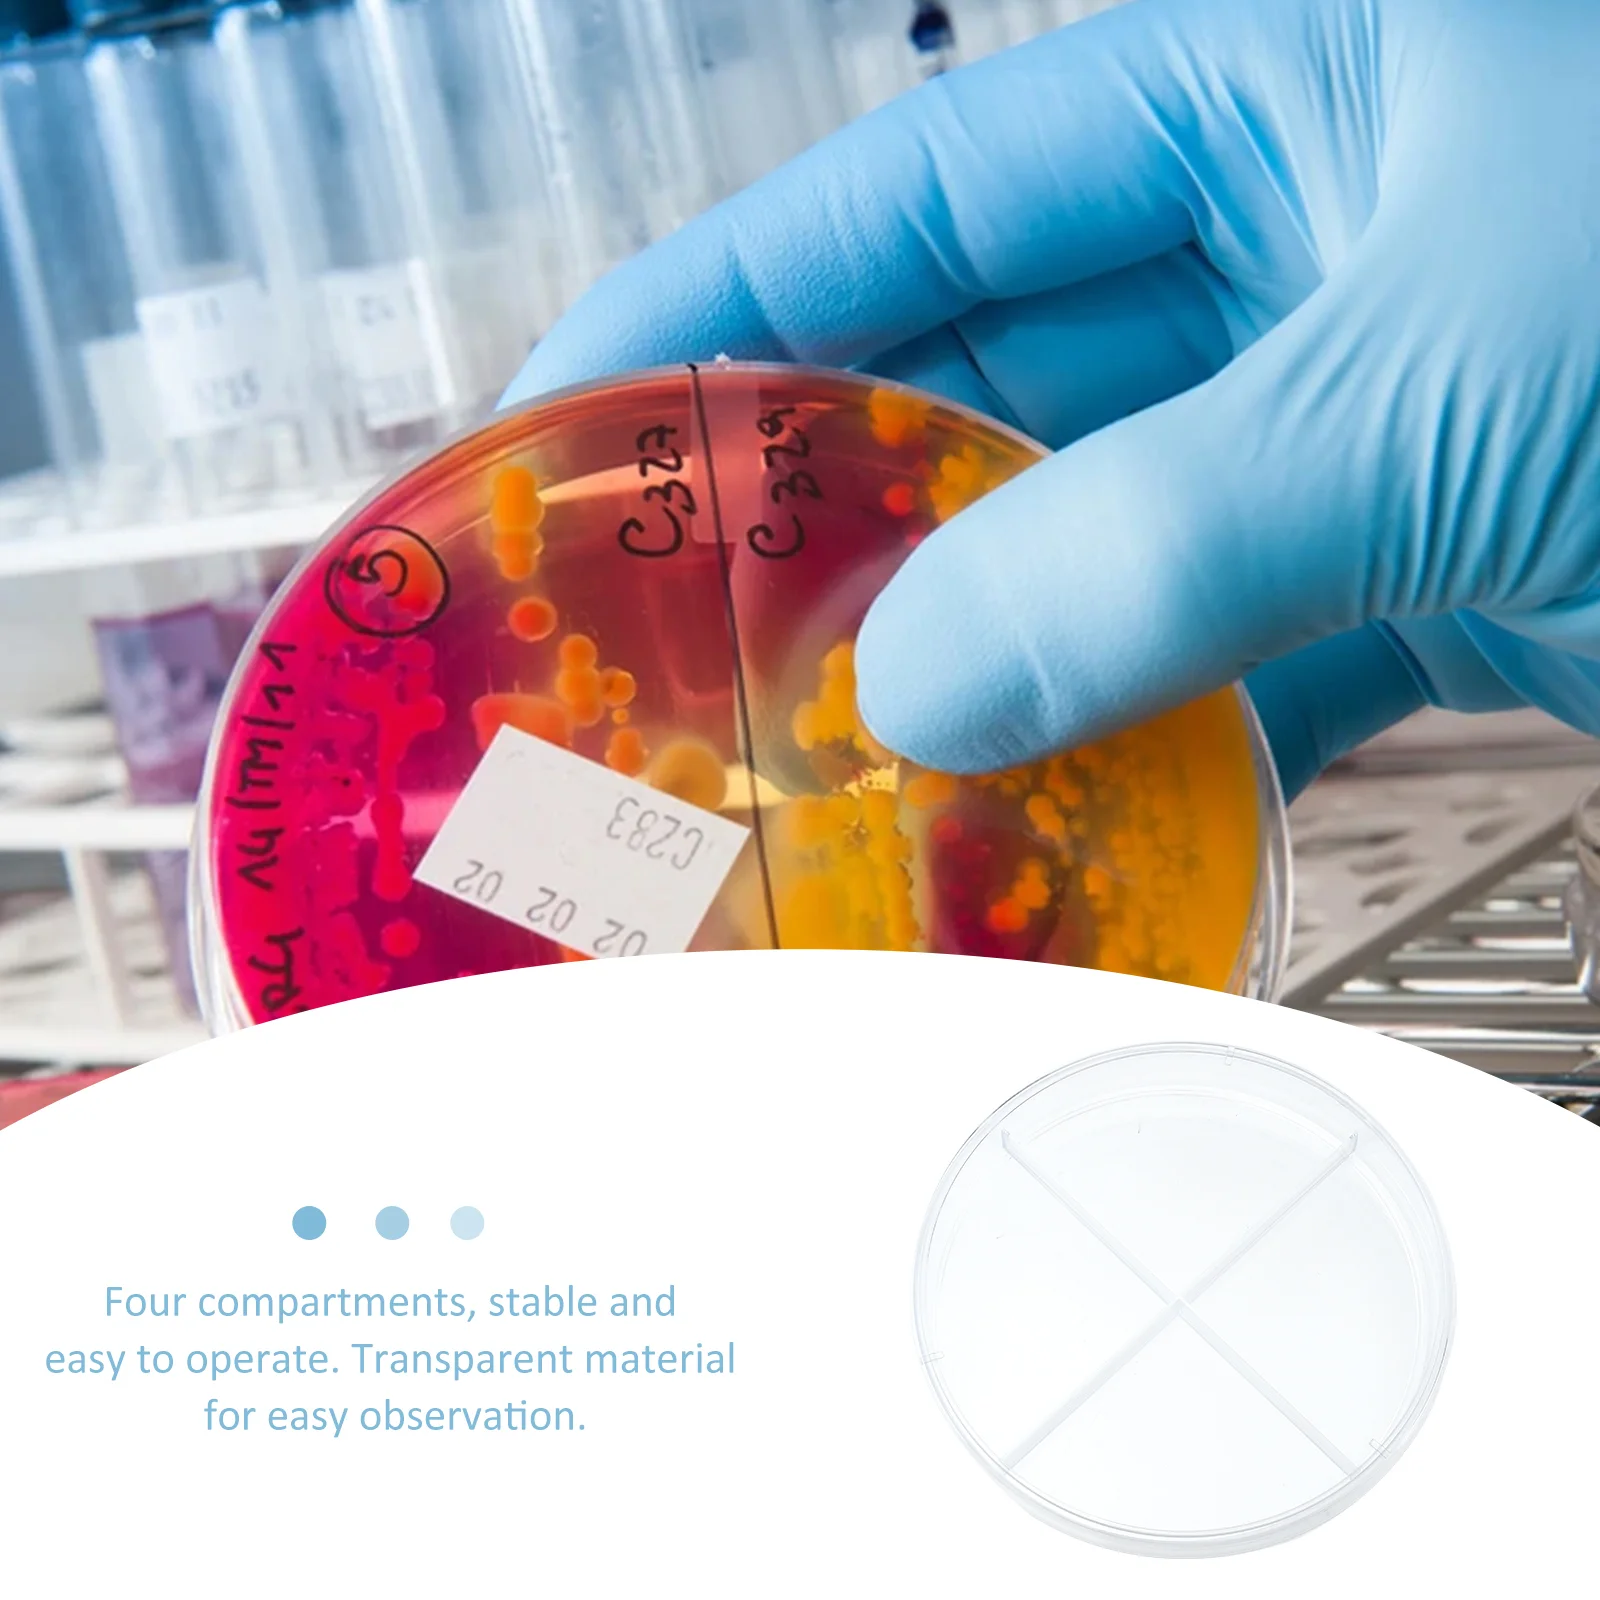

10-шт. инструмент для научных экспериментов, клеточная культура, чашка Петри, школьная пластиковая клеточная культура
Price history chart & currency exchange rate
Customers also viewed

$369.58
Пневматические тиски, быстрое крепление, фрезерный станок, угловой фиксированный тип, тиски, быстродействующие пневматические плоскогубцы, зажим ЧПУ
aliexpress.ru
$1.84
Metal Square Framed Glasses Women Girl Exquisite Retro Narrow Framed Eye Glasses Daily Simple Versatile Anti-Blue Glasses Gift
aliexpress.ru
$1.68
Держатель для ручек, подставка для ручек, кошка, милые настольные аксессуары, органайзер, забавный держатель для ручек, канцелярские принадлежности для студентов, офисное хранение
aliexpress.ru
$38.59
Nordic Rattan Weaving Pattern Horse Resin Decoration Organizador Study TV Cabinet Wine Cabinet Home Soft Decoration Furnishings
aliexpress.com
$454.04
Современный удобный стул для отдыха, короткое плюшевое бархатное кресло с поясничной подушкой для гостиной
aliexpress.ru
$1,550.00
2014 2015 2016 для BMW M4 Полный фонарь автомобильное освещение 435i 428i 420i фара в сборе фара
aliexpress.ru
$13.15
Sanrio, чехол для Apple 9.7 ipad с Hello Kitty, полноразмерный защитный чехол для Air2 Mini 4 5 комплектов Air10.5 Cortex, противоударный мягкий чехол
aliexpress.ru
$2.76
1Pcs Suitable For Apple Pencil Pen Sleeve Apple Generation Business Pen Cap Case Ipad Touch Screen Silicone Pen Sleeve
aliexpress.ru
$3.36
Коллекционная игрушка Hot Wheels 70th Honda Cr-x Civic EF Civic SI Monkey Z50 Racer Honda S2000 Honda Odyssey 1:64, коллекционная игрушка FKD22
aliexpress.ru
$1.01
Говорящая искусственная игрушка для снятия стресса с языка Мягкий шар для детей и взрослых детская игрушка 2021 горячий стиль забавные игрушки
aliexpress.ru
$1.24
Щетки для чистки ресниц 3 шт., щетки для носа, средство для чистки черных точек, ресниц
aliexpress.ru
$15.93
5 шт., 100% оригинальная новая модель телефона A3959SLBT A3959 SOP-24, чип драйвера двигателя постоянного тока
aliexpress.ru
$13.43
Детская футболка, Новинка лета 2022, модные детские футболки с коротким рукавом и мультяшным принтом, детская одежда с рисунком в Корейском ст...
aliexpress.ru
$51.10
wide leg pants turtleneck blouse casual pleated suit women's spring two piece female loose streetwear 2a7070 210507, White
dhgate.com
$50.47
shopping bags large tote bag women designer handbags men beach summer travel shoulder canvas purse wallets 230505
dhgate.com
$70.37
designer bag ins super three in one package 2023 popular new underarm bag versatile fashion bag women's chain one shoulder crossbody ba
dhgate.com